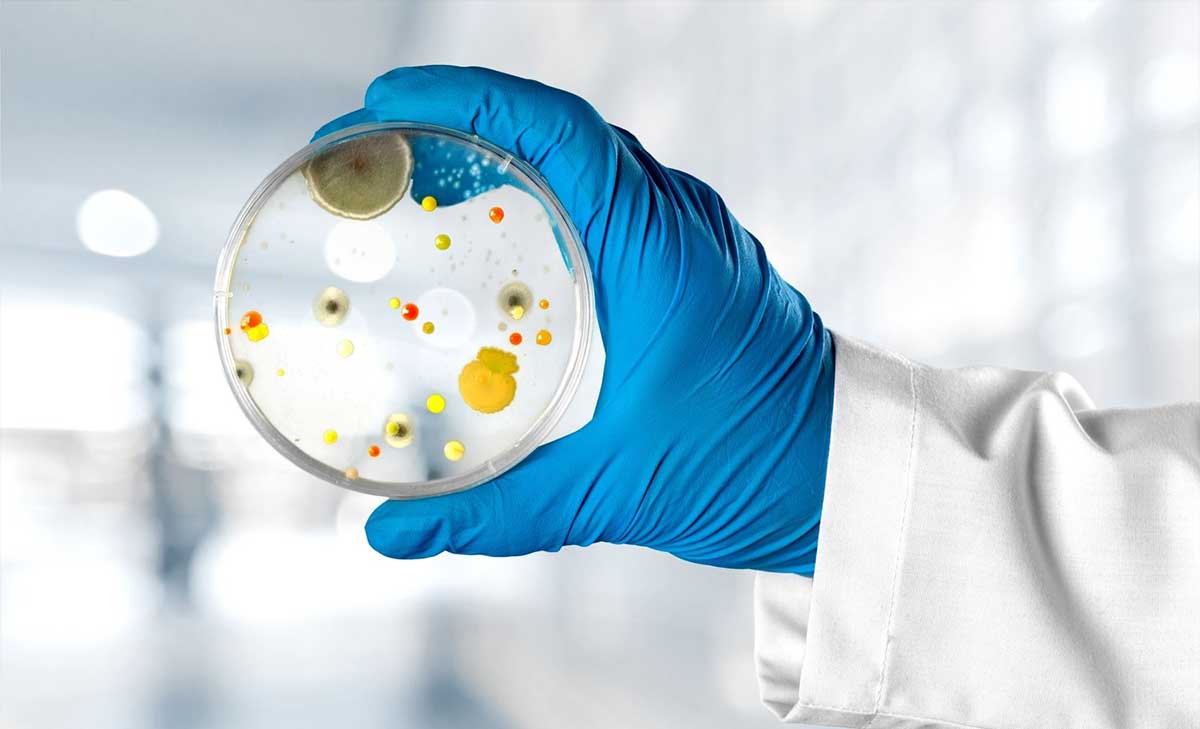

Insurance Coverage
When you’re a homeowner, water can be one of your biggest nightmares. Polls show that the average person experiences a

When you’re a homeowner, water can be one of your biggest nightmares. Polls show that the average person experiences a

We are continuously working with medical professionals to discuss the safety data sheets of the products in our marketplace. Mold’s

Scientific and clinical studies have evolved over the years to show that certain species of mold and their byproducts can

One of the most conflicted arguments discussed in the mold industry today is what to do with belongings after remediation.

You’ve done the legwork. You know what mold is. You know how it can affect your health. You know there’s

MYCOTOXINS WHAT ARE MYCOTOXINS? Mycotoxins are toxic compounds naturally produced by fungi that are capable of causing a wide range

Covid-19 took the world by storm. Millions have died as a result of the virus since its inception, and with

Bacteria and its byproducts are often overlooked during remediation protocols, but it’s a massively important part of detoxifying a home.

Currently, there is no certification for removing mycotoxins. These microscopic toxins are harmful toxic byproducts produced by certain species of
If you want to win the war, you have to understand the enemy. When you’re up against mold, you need